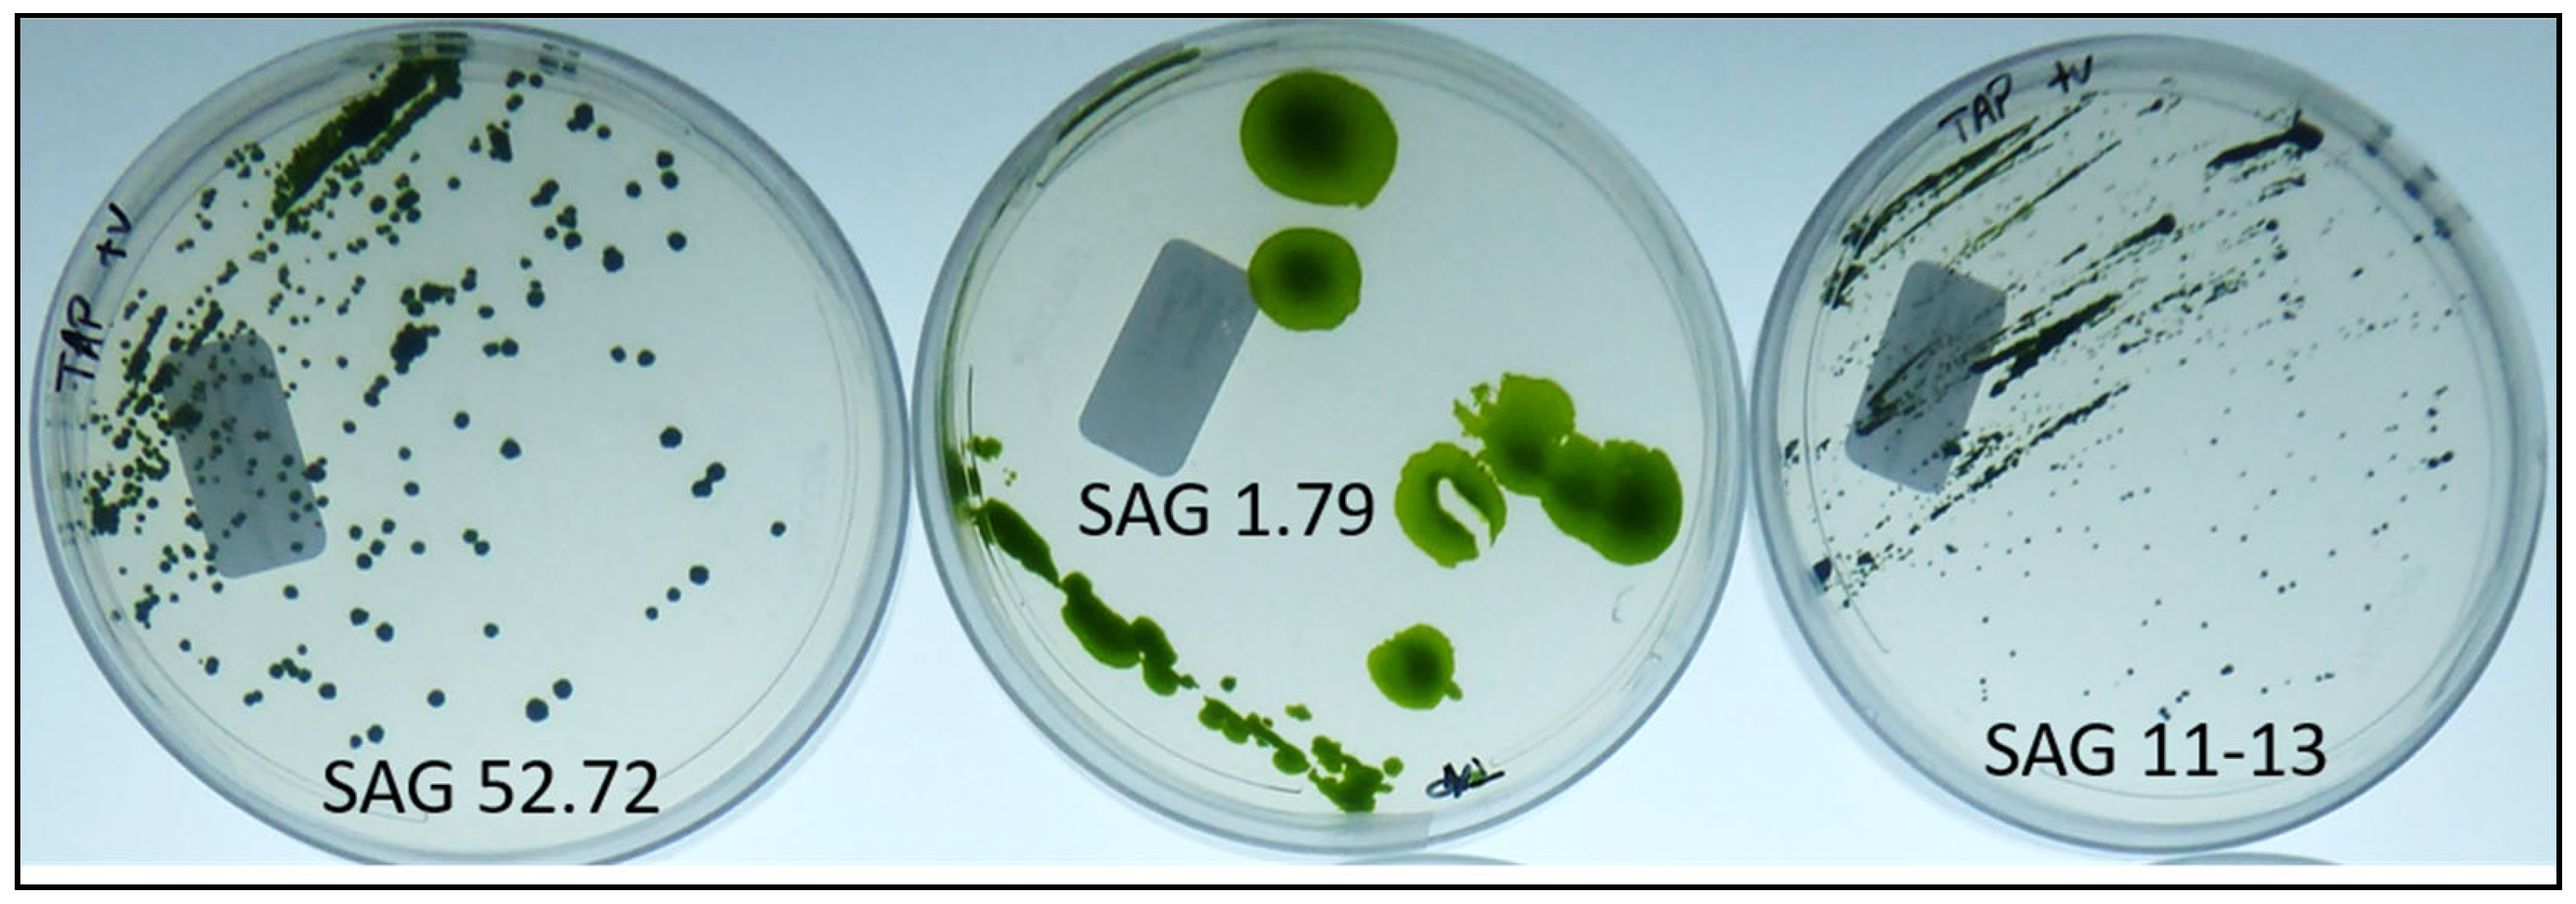
Polysaccharides 02 00009 g001

1. Introduction
Polysaccharides (PS) are long chains of linear or branched sugar monomers linked through glycosidic bonds. Depending on the composition, size, and structure, PS can have a range of physico-chemical properties including antioxidant, stabilizing, suspending, thickening, flocculating, encapsulating, emulsifying, and water retention [
1]. Some PS also possess biological activities such as antiviral, anticoagulant, immunomodulating, and antitumoral activities [
2]. Due to these characteristics, PS can be used in a variety of different commercial applications, including biomedical devices, pharmaceuticals, cosmetics, adhesives, detergents, food additives, textiles, brewing, and wastewater treatments [
1].
Hyaluronan (HA) is a linear, polydisperse, high molecular weight (MW) glycosaminoglycan (GAG), composed of alternating repeats of β-1,4-D-glucuronic acid and β-1,3-N-acetyl-D-glucosamine units [
3]. In addition to being highly biocompatible and biodegradable, the basic physicochemical properties of HA that are of relevance to biomedical applications are related to viscosity, elasticity, lubrication, and its high capacity for water retention [
4].
Lobochlamys segnis (L.s.), previously known as
Chlamydomonas segnis [
5], is a freshwater, green microalgae that was considered in the past for its fatty acid profile rich in polyunsaturated fatty acids (PUFAs) [
6]. Under general stress conditions, such as high light intensities or nitrogen starvation, the cultivation of this species becomes difficult due to the substantial production of extracellular polysaccharides (EPS; thought to be HA or HA-like) that increase the viscosity of the culture [
7]. This was considered to be a limitation during the production of PUFAs [
8].
In this study, rather than viewing the EPS as a problematic by-product, we sought to evaluate L.s. as a platform for its optimised production and assessed its potential for exploitation. In the first instance, the effects of culture conditions and media composition were tested in order to increase the biomass concentration in stationary phase. After that, a panel of stress-inducing conditions were applied and the appearance of the culture was evaluated, with the aim of reaching high culture viscosity due to EPS production. Once the EPS production was increased, extraction and purification conditions were determined. Purified EPS was characterised for its sugar composition, molecular weight (MW), and glycosidic linkages. Rheological properties and antioxidant activity were also determined and directly compared with those for HA. Interest in alternatives to traditional HA is fuelled by current challenges associated with its production as well as achieving monodisperse high MW product of high purity. In a market expected to reach USD 16.6 billion by 2027 [
9], these two aspects make the exploration of alternative HA supply chain sources, or new methods for its production not only scholastically intriguing but also relevant based on the industrial and economic potential.
Based on our results, the EPS produced by Lobochlamys segnis under stress conditions is not HA, being, rather, a branched complex high MW polysaccharide. We discuss possible applications for the purified EPS as a biomedical functional alternative to HA as well as its potential as an antioxidant, preservative, water retention agent, or thickening agent in food and/or cosmetics.
2. Materials and Methods
2.1. Chemicals
Culture media components were purchased from VWR, UK. Proteinase K was purchased from New England Biolabs, UK. All other chemicals and enzymes used were purchased from Merck, UK.
2.2. Microalgae Strain Selection and Growth/Stress Conditions Determination
Three strains of L.s. were initially obtained from the culture collection of algae at Goettingen University (SAG) [
10]: SAG 52.72 isolated in Czech Republic, SAG 11-13 isolated in United Kingdom, and SAG 1.79 isolated in Canada. All three strains were kept on Tris-acetate-phosphate (TAP) medium [
11] 1.5% agar plates and re-streaked every month.
Two media, prepared as per reference, were tested, TAP medium [
11] and High salt medium (HSM) [
12]. Three nitrogen sources were tested for TAP medium, all at the same molar concentration as per reference. Cultures were grown in Algem
® HT24 photobioreactor [
13] in 25 mL volume inside a 50 mL clear flask or Algem PRO photobioreactor [
13] in 400 mL volume in a 1 L Pyrex erlenmeyer flask, at 28 °C with white LED light intensity set at 200 micromoles/m
2/s (µM/m
2/s microEinsteins [µE]) photosynthetically active radiation (PAR) measuring the OD at 740 nm every 10 min. As a stress inducer, 4000 µE light intensity was applied with red:blue:white ratio of 1:1:2 in the Algem photobioreactor. The mixing was set to 120 rpm with a gas aeration rate of 25 mL/min of 30% CO
2 in order to control the pH of the culture at pH 7 via computer-controlled solenoid valve. For the acetic acid feeding, a 1 molar solution was prepared in purified water and used under the control of a modified version of the Algem software with a peristaltic pump [
13] in order to keep the pH of the culture at 7 and with a continuous aeration rate of 50 mL/min of air.
2.3. Extraction of Extracellular Polymeric Substances
All samples, except when specified, were extracted at 37 °C mixing with a magnetic stir bar for 24 h. All enzymatic and non-enzymatic extraction processes were tested independently under the following conditions:
Lysozyme lyophilized powder from chicken egg white was resuspended at 10 mg/mL in 10 mM Tris-HCl pH 8 immediately before use and was used at 1 mg/mL in solution with EPS.
Lyticase powder from Arthrobacter luteus was resuspended at 10 mg/mL in 67 mM Potassium Phosphate Buffer pH 7.5 immediately before use and was used at 1 mg/mL in the same buffer solution with EPS at 25 °C.
Sulfatase powder from Helix pomatia was resuspended at 10 units/mL in 200 mM Sodium Acetate Buffer, pH 5.0 immediately before use and was used at 1 unit/mL in buffer solution with EPS.
Chitinase powder from Streptomyces griseus was resuspended at 1 mg/mL in purified water immediately before use and was used at 0.5 mg/mL in solution with EPS.
Proteinase K was used at 3 units/mL in 15 mM Tris-HCl pH 7.6, 1.5 mM CaCl 0.6% SDS solution with EPS.
Hyaluronidase from bovine testes was resuspended at 1 mg/mL in 20 mM phosphate buffer, pH 7, with 77 mM sodium chloride and 0.01% BSA immediately before use and was used at 0.5 mg/mL in solution with EPS.
Sodium dodecyl sulphate (SDS) at 1% or 6% final concentration in water.
Applying heat at 100 °C for 6 h or 24 h or 121 °C for 15 min every 100 mL in autoclave.
Urea at 1 M and 10 M final concentrations.
Potassium hydroxide (KOH) 5% final concentration.
Sodium chloride (NaCl) 2 M final concentration.
After extraction, samples were centrifuged once at 21,000 relative centrifugal force (rcf) for 5 min. The un-extracted part of the sample (cells and cell debris) formed a pellet and the extracted EPS was in solution in the transparent supernatant.
2.4. Agarose Gel Electrophoresis
A TBE buffer gel was prepared with 0.5% agarose and run for 1 h at 160 volts. Samples were prepared adding 1 volume of loading dye, composed of 2 M sucrose in TBE (1×) with 1/20 of final volume bromophenol blue, to 5 volume of sample. The gel was equilibrated in a Petri dish at room temperature, mixing for 1 h with 40% ethanol in purified water. The gel was stained with Stains-All (Merck, UK) working solution at room temperature for 24 h; 0.1% Stains-All stock solution was prepared in formamide (10 mg in 10 mL), for working solution, 2.5 mL of stock solution, 2.5 mL formamide, 12.5 mL isopropanol, 0.25 mL of 3 M Tris-HCl pH 8.8, and 32.25 mL of purified water were mixed. The gel was de-stained with light for 10 min after rinsing with water first and then with 70% denatured ethanol.
2.5. Filtration
An extracted sample was clarified with a glass microfiber 0.45 μm filter. After clarification, the extracted samples were filtered with a Minimate 500 kDa tangential flow filtration (TFF) capsule (Pall Corporation) following manufacturer’s recommendations, until reaching a reduction of volume of 90%. Purified water was used to reconstitute the concentrate to the original volume, twice, in order to remove low MW contaminants and to desalt. The filtrate was collected for further processing with a 30 kDa molecular weight cut-off capsule as described for the previous filtration process.
2.6. High MW EPS Purification with Sephacryl Size Exclusion Chromatography
A glass column with 46 cm length and 1 cm internal diameter was used with Sephacryl® 500-HR (Merck, UK) and 0.15 M NaCl, 0.05 M phosphate pH 7 running buffer with a flow rate of 2 mL per minute; 0.3 M NaCl final concentration was added to each sample before loading on the column. One millilitre fractions were collected and precipitated by addition of 3 volumes of acetone and centrifugation at 4600 rcf. After the supernatant was removed, the pellet was air-dried and resuspended in TBE at 4 °C overnight followed by gel electrophoresis analysis as described above. Once the fractions with the higher molecular weight product were selected, the samples were pooled and desalted with TFF as previously described.
2.7. Freeze Dry
Purified high MW EPS was frozen at −40 °C and dried in a lab scale vacuum freeze dryer (Harvest Right, UT, US) at −5 °C heating shelf temperature, 200 mTorr cavity pressure, and −40 °C cold trap temperature for 24 h in a glass Petri dish.
2.8. Polysaccharide MW Analysis
One mL of 0.1 M NaNO3 was added to the freeze-dried polysaccharide sample; it was heated up to 100 °C for complete dissolution and centrifuged for 10 min at 14,000 rcf. The supernatant was collected for analysis, with 0.1 mL injected per sample; this was performed with GPC-RI-MALS platform with the column temperature set to 60 °C, 0.1 M NaNO3 mobile phase with a flow of 0.4 mL/minutes. From the comparison of the retention time of the EPS sample with the same data from a set of standards of known MW solution, it was possible to determine the MW distribution of the sample.
2.9. Glycosyl Composition Analysis
Analysis was undertaken by combined gas chromatography/mass spectrometry (GC/MS) of the per-O-trimethylsilyl (TMS) derivatives of the monosaccharide methyl glycosides produced from the sample by acidic methanolysis [
14,
15]. Approximately 0.25 mg of the sample was heated with methanolic HCl in a sealed screw-top glass test tube for 17 h at 80 °C. After cooling and removal of the solvent under a stream of nitrogen, the sample was treated with a mixture of methanol, pyridine, and acetic anhydride for 30 min. The solvents were evaporated and the sample derivatized with Thermo Tri-Sil HTP (HDMS:TMCS:Pyridine) reagent at 80 °C for 30 min with added inositol as internal standard. GC/MS analysis of the TMS methyl glycosides was performed on an Agilent 7890A GC interfaced to a 5975C MSD, using a Supelco Equity-1 fused silica capillary column (30 m × 0.25 mm ID).
2.10. Glycosyl Linkage Analysis from Creative Proteomics
Approximately 1 mg of sample was treated with 0.5 M methanolic HCl for 20 min at 80 °C. It was then dried, and reduction of the newly formed carboxylic esters was accomplished using 0.4 mL of a 10 mg/mL solution NaBD4 in water overnight. The sample was neutralised with acetic acid, dried thoroughly, and later suspended in 0.2 mL of dimethyl sulfoxide. Per-methylation of the sample was affected by two rounds of treatment, first with sodium hydroxide for 15 min and then with methyl iodide for 45 min. The sample was hydrolysed using 0.1 M TFA for 30 min in a sealed tube at 100 °C, reduced with NaBD4, hydrolysed again using 2 M TFA for 2 h in a sealed tube at 100 °C, and acetylated using acetic anhydride/TFA [
16,
17]. The resulting partially methylated alditol acetates (PMAAs) were analysed on an Agilent 7890A GC interfaced to a 5975C MSD (mass selective detector, electron impact ionization mode); separation was performed on a 30 m SP2330 bonded phase fused silica capillary column.
2.11. Rheology Analysis
Flow sweep measurements of viscosity were implemented using Discovery HR-3 hybrid rheometer with a hard-anodised aluminium 40 mm Peltier parallel plate with Solvent Trap. The gap was set to 500 µm and the analysis was performed with samples at 25 °C with a shear rate changing between 0.1 to 1000 s−1 measuring 5 points per decade, with equilibrium time of 1 min. One millilitre of the sample was loaded and the excess was wiped out. HA standard solution was made dissolving pure 5 MDa MW HA at a concentration of 8.34 mg/mL in purified water. L.s. stressed cells were resuspended in TAP medium. L.s. EPS was extracted with heat treatment, debris was filtered, and the clear solution was concentrated with 500 kDa molecular weight cut-off membrane at about 14 mg/mL. NaCl was added to the samples to a final concentration of 2 M to investigate the impact on the viscosity of the solution.
2.12. Antioxidant Capacity and Reducing Power Quantification Assays
Heat extracted L.s. EPS samples were concentrated with 500 kDa filter and freeze-dried without purification in order to resuspend them in purified water at a known concentration for measurement of total antioxidant capacity and reducing power. The total antioxidant capacity was measured based on the reduction of Mo
6+ to Mo
5+ [
18]. Aliquots of the polysaccharide solution (0.1 mL) at different concentrations (0.5%, 0.75%, 1%, 1.25%, 1.5%) were mixed with 1 mL of the reagent solution (0.6 M sulfuric acid, 28 mM sodium phosphate (NaH
2PO
4), and 4 mM ammonium molybdate). This step was followed by incubation at 95 °C for 90 min. Subsequently, the absorbance was read at 695 nm. A standard curve under the same conditions was prepared with solutions of ascorbic acid (0.005%, 0.004%, 0.01%, 0.0125%, 0.015%) in purified water. The assays were carried out in triplicate and the results are presented as equivalence of ascorbic acid (mg EAscA/g of sample).
The reducing power was determined according to published method [
19]. Two hundred microliters of EPS in purified water (1.5%, 15 mg/mL) were mixed with an equal volume of both 0.2 M sodium phosphate buffer (pH 6.6) and 1% potassium ferricyanide (10 g/L). The mixture was incubated at 50 °C for 20 min. After cooling down the samples, 200 microliters of 10% trichloroacetic acid (
w/
v) were added, the mixture was centrifuged at 21,000 rcf for 10 min; 0.5 mL of each supernatant was moved to a new tube and, with added 0.5 mL purified water and 0.1 mL of 0.1% of ferric chloride, samples were mixed and the absorbance was measured at 700 nm. A standard curve was prepared with solutions of ascorbic acid (0.005%, 0.0035%, 0.002%, 0.0009%, 0.0007%) in purified water. The assays were carried out in triplicate and the results are presented as equivalence of ascorbic acid (µg EAscA/g of sample).
3. Results
3.1. Microalgae Strain Selection and Growth/Stress Conditions Determination
Polysaccharide production in
Chlamydomonas strains has previously been reported [
20,
21].
Lobochlamys segnis is a microalga that is closely related to
Chlamydomonas [
5] and has been reported to produce an HA-like capsule under stress conditions [
7]. The only other report of HA being produced within the plant kingdom, and indeed, within another green microalga, occurs when
Chlorella variabilis or close relatives are infected by Chlorella viruses carrying a viral HA synthase gene [
22]. While PS production in the latter occurs following transfer of the HA machinery via the viral genome, the observation of inducible HA-like polysaccharide production in the former raised the possibility of a native algal-encoded HA synthase pathway and potentially a natural source and route to a novel supply chain for this valuable polysaccharide. To investigate this possibility, three different strains of L.s. were obtained from the SAG culture collection. Of these, SAG 1.79 has previously been noted in a Canadian patent to produce a HA-like substance referred to as Chlamyhyaluronic acid [
7], while the two other closely related strains were ordered for comparative purposes. On receipt, the identity of each strain was confirmed by 18S PCR sequencing and maintained on agar plates for several generations. Under long term cultivation conditions, the SAG 1.79 strain was confirmed to grow as mucoid colonies. In contrast, the two other strains did not exhibit the same appearance (
Figure 1). This provided a quick primary screening method for strains displaying EPS production, and SAG 1.79 was selected for further investigation. Growth was tested in two different liquid media: HSM (no carbon source) and TAP (acetate as carbon source).
Three different nitrogen sources were tested as substrate for growth at the same molarity in TAP medium: ammonium chloride (NH
4Cl), potassium nitrate (KNO
3), and urea (CO(NH
2)
2). The growth rate as well as the cell density at stationary phase were the same for all three conditions, as shown in
Figure 2.
Growth in the dark was also tested utilising acetate and glucose independently as carbon sources. As shown in
Figure 2, SAG 1.79 was not able to utilise glucose from the medium for growth. In contrast, the strain was able to use acetate in the dark, although showing a higher doubling time, indicating a slower growth rate. This suggests that SAG 1.79 is capable of preferential mixotrophic growth using light coupled with acetate as a carbon source. Mixotrophic growth was about three times faster than growth in the dark with acetate or the one in the light without carbon source.
This observed behaviour suggests a synergistic effect of acetate and light, giving a higher response than a predicted additive effect when the two were used together at the same time. The possible explanation for this behaviour could be that the strain is using acetate as carbon source through the respiration pathway producing CO
2 that will be used for photosynthesis using light [
23,
24].
The doubling time (T
d) for each curve, summarised in
Table 1, was calculated from data drawn from the linear portion of the growth curves (between 0.5 day and 0.75 day) using the following formula:
Based on the information collected from these preliminary data, the nitrogen amount in the medium does not appear to be limiting the biomass density at the stationary phase; instead, the limiting factor could be the acetic acid that is the carbon source together with the CO
2 from the air. A strong light stress was applied to the culture after it reached the stationary phase in order to stimulate the production of EPS. When this stress was applied, the appearance of the liquid culture did not seem to change. It is reported that a high carbon to nitrogen ratio (C/N) stimulates EPS production due to nitrogen limitation [
25]. A further trial was carried out feeding the culture with acetic acid, keeping the pH constant at 7 using the Algem lab scale photobioreactor.
A few days after the culture reached stationary phase with acetic acid feeding, the Algem OD reading reached higher values compared to the cultures that were not fed with acetic acid (
Figure 3a) showing higher viscosity behaviour (
Figure 3b). Specifically, centrifugation at 21,000 rcf for 5 min was not sufficient to achieve a stable cell pellet. Further, light microscopy revealed cells that appeared to be evenly spaced, as if surrounded by something not visible to the eye, which caused the cells to distribute within the culture medium as if they were kept physically apart—presumably by an extracellular capsule (
Figure 3c,d) forming a physical barrier.
In an effort to visualise a hypothesised capsule around the cells, a 10 µL sample of each culture was diluted with 1 volume of India ink (
Figure 3e,f). India ink is composed of small black particles resuspended in water that give a black background, and that would be excluded from areas occupied by a viscous physicochemical barrier such as that created by an extracellular polysaccharide capsule.
Using this technique, it was confirmed that, when stressed, cells were surrounded by a capsule that excluded the ink particles from the cell surface.
3.2. Determination of Extraction and Purification Conditions
In order to assess the nature of the EPS produced and reduce the viscosity of the culture, the stressed culture was exposed to a panel of enzymes and chemical treatments that degrade specific polymers. Susceptibility to the action of lysozyme, lyticase, sulphatase, chitinase, Proteinase K, hyaluronidase, 1 and 6% SDS, heat, urea 1 and 10 M, 5% KOH and 2 M NaCl were assessed. After the respective treatments, samples were centrifuged at 21,000 rcf for 5 min. The presence of an obvious cell pellet was taken as an indication that the EPS was separated from the cells; this was possible after the extraction with heat, SDS, urea, NaCl and KOH, with the best result achieved through applying heat alone, 100 °C for 24 h or autoclave at 121 °C for 15 min/100 mL. Under this condition, a higher amount of the EPS was separated from the biomass compared with the other conditions. None of the enzyme digestions separated the capsular EPS from the cells nor acted to degrade the EPS. EPS extracted with heat was used for further evaluations and showed an apparent degradation pattern as seen through agarose gel electrophoresis in
Figure 4.
The fact that the EPS was able to migrate within an agarose gel electrophoresis set-up using TBE buffer suggested that it possesses a net negative charge consistent with it being a polyanion. This is similar to HA or other glycosaminoglycans.
Five hundred kDa and 30 kDa crossflow filtrations were tested sequentially for EPS purification from small MW contaminants. All the extracted EPS seemed to be bigger than 30 kDa. Due to the high viscosity and heterogeneity of the sample, filtration was not very efficient to separate high from low MW molecules. As shown in
Figure 4, with 500 kDa filtration, most of the high MW EPS was retained, but the low MW contaminants were still present. With the 30 kDa filtration, everything was retained.
In order to purify high MW EPS from low MW EPS and contaminants, preparative size exclusion chromatography was tested. The different fractions were collected and assessed via gel electrophoresis (
Figure 5a). All high MW fractions were pooled, washed, and resuspended in purified water (
Figure 5b). The solution appeared viscous, colourless, clear, and free of any noticeable fragrance. After freeze-drying, the EPS appeared as a white aggregate that dissolved as soon as it was in contact with water (
Figure 5c). The yield of purified EPS was about 1 g/L of stressed culture.
3.3. Molecular Size Determination and Conformation Analysis
The number-average MW (Mn), used for kinetics studies and stoichiometric calculations, and the weight-average MW (Mw), used to determine tensile strength, were measured and polydispersity (Mw/Mn), that is a measure of the broadness of the molar mass distribution, was calculated.
Mn was calculated as 3.673 × 106 (±1.640%) Dalton (Da) or g/mol with a polydispersity of 2.987 (±24.970%).
The maximum MW registered was higher than 100 megadalton (MDa) (
Figure 6), but the average MW was about 3.7 MDa. This suggests that the extraction protocol may degrade or fragment the EPS as well as separating it from the cells. Improvement of the extraction protocol could increase the average MW value, altering its rheological properties and potentially enabling its application in an expanded range of cosmetics, biomedical, or food related product development opportunities.
The shape of the molecule can be assessed based on the relationship between the measured molar mass and root-mean-square (RMS) radius. A plot of the log of RMS radius in nanometres (nm) as a function of the log of the molar mass expressed in g/mol, called a Conformation Plot (
Figure 7), shows the relationship between the two values. The slope of this graph gives a good estimate of the shape. The slope calculated for this sample is 0.55, suggesting a flexible random coil structure. If the slope was about 0.33, it would have suggested a branched spherical shape, and a slope of 1 would have suggested a rigid linear rod shape [
26,
27].
3.4. Glycosyl Composition and Glycosyl Linkage Analyses
The freeze-dried sample was hydrolysed and analysed (
Figure 8). The saccharides found in the sample were galactose, glucose and glucuronic acid along with an unidentified pyruvate containing hexose residue.
The estimated amounts and mole percentage of each detected monosaccharide in the sample is summarised in
Table 2.
Notably, N-acetylglucosamine was not detected in the sample, demonstrating that this EPS is not HA as was previously suggested [
7] and is also not a glycosaminoglycan.
Glycosyl linkage analysis was performed to identify the structure of the polysaccharide (
Figure 9). The results, summarised in
Table 3, are consistent with the previously reported composition data (
Table 2). The presence of the 3,4,6 linked galactopyranosyl residue and the abundance of terminal sugars suggests that the structure of the polysaccharide is complex-branched. It is possible that some of the linkages were disrupted by the strong and non-specific extraction process. There is also no clear evidence of a regular repeat pattern of the glycosyl linkages.
3.5. Rheology Analysis
Rheological properties of the extracted L.s. EPS were explored to assess its potential for use within a cosmetics or personal care product formulation.
Non-stressed L.s. culture, even at high cell density, showed a normal water-like behaviour. A few days after the culture entered stationary phase with continued acetic acid feeding, the cultures displayed higher viscosity. The viscosity of the stressed cell cultures and the extracted raw EPS were measured as explained in the materials and methods section using water (Newtonian fluid) and HA solution (non-Newtonian fluid) as standards. Extracted, non-purified EPS shows a viscosity higher than water with a non-Newtonian trend at higher shear rate, similar although lower compared to the pure HA solution. Stressed algae cell cultures, at low shear rates, showed a higher viscosity compared to HA solution but it showed a different trend with the increase of the shear rate, probably due to the presence of the cells inside the EPS capsule (
Figure 10).
The high viscosity of the stressed cells suggests that, if a way to extract higher MW EPS could be found, the viscosity of pure, higher MW L.s. EPS could be equivalent or even higher than that of the HA solution.
The effect of the addition of higher salt concentrations, 2 M NaCl, on the viscosity was investigated in order to further understand the behaviour of the L.s. EPS under different conditions and to potentially optimize and improve the extraction protocol. In addition to salt, other compounds that could be tested for their ability to reversibly lower the relative viscosity of the solution are SDS and urea.
With NaCl addition, the viscosity of the stressed cells decreased considerably (
Figure 11), showing a change that could impact positively upon the extraction costs, lowering the energy required for liquid pumping and mixing expenses.
In contrast, the effect on the EPS solution was milder at a high shear rate, which could be interpreted as the mixing during extraction, suggesting that optimisation and further investigation are needed to clarify the effects.
3.6. Antioxidant Capacity and Reducing Power Quantification Assays
Total antioxidant capacity and reducing power of purified high MW EPS were measured with in vitro assays.
As shown in
Table 4, a purified high MW EPS sample showed 100 times less antioxidant capacity compared to pure vitamin C. Other values are reported in the same table for reference.
Another way to measure the antioxidant activity of a compound is the reducing power.
Table 5 shows the measured value for purified high MW EPS and a value from literature as reference.
4. Discussion
In this study, Lobochlamys segnis was investigated for the production of EPS. Culture and stress conditions were evaluated, different extraction and purification protocols were determined, and EPS was characterised, including assessment of commercially relevant properties.
The best growth and stress conditions were determined to be mixotrophic growth using acetate as the carbon source and carbon-feeding-rate controlled by pH value as this approach increased the C/N ratio, thereby inducing the nitrogen-limitation-based stress on the cells. In a large-scale setting, an improved heterotrophic protocol in fermenters could be more effective in optimizing L.s. growth and stress conditions.
The extraction and purification methods utilised are relatively complicated and expensive with regard to materials and energy required, and could limit exploitation to high-value applications.
While heat extraction was identified as the best option for small scale extraction, translation to a larger scale may require super-heated water extraction, which is relatively energy expensive. Since SDS, NaCl, and urea can be used to partially separate EPS from the cells, an optimised extraction carried out in conjunction with heat could be explored to lower the extraction temperature, decreasing time and costs.
Tangential flow filtration and size exclusion chromatography proved suitable as purification techniques, which bodes well for the development of a large-scale industrial process.
A process to cheaply and reversibly lower the viscosity of the solution would positively influence the costs involved with this step and have a substantial impact in the overall cost of production.
Growth and stress conditions of the microalgae culture were determined. In order to improve production, extraction, and purification, multifactorial experiments should be performed so that the key factors for each step can be identified and optimized. Preliminary results of L.s. EPS and L.s. stressed cells showed interesting rheological properties, and further investigations are needed, including characterisation of biocompatibility, toxicity, elasticity, plasticity, and lubrication properties in order to expand its possible application.
There is interest in the cosmetic industry for low cost, naturally-sourced thickening agents that are clear, colourless, and of neutral fragrance [
30]. The extracted L.s. EPS sample appears to satisfy these criteria and shows potential as a future ingredient.
Antioxidants are often used as preservatives in food and cosmetics and as active ingredients in cosmetics because of their skin protection properties [
31,
32,
33], with ascorbic acid (vitamin C) being the most powerful, most widely used, and least toxic natural antioxidant [
34]. Other natural compounds with high antioxidant activity are tocopherols, carotenoids, and flavonoids [
34]. The antioxidant activity of this compound is significant and could help in cosmetic formulations, lowering the costs of other antioxidant agents that need to be added.
Although the capsular PS produced by L.s. was initially suggested to be HA, our work here has shown this assumption to be incorrect. While the colour of the stained product as visualised in agarose gel electrophoresis is similar to HA, when gel migration is used, the EPS products are clearly distinguishable. Indeed, the maximum MW of the purified L.s. EPS measured (over 100 MDa) is vastly different from that observed for HA, 10 MDa in
Heterocephalus glaber [
35]. Glycosyl composition analysis confirmed this definitively by determining the presence of galactose and glucuronic acid with traces of glucose rather than the alternating repeats of β-1,4-D-glucuronic acid and β-1,3-N-acetyl-D-glucosamine units characteristic of HA.
The thickening property of the high MW L.s. EPS is an interesting phenomenon, along with the antioxidant property and so far, L.s EPS characteristics can be considered as amenable to its use as a HA alternative. Both of these properties need to be more thoroughly analysed with additional characterisation for new applications being fundamental in order to fully understand and exploit the compound, together with the investigation of biocompatibility and non-toxicity of the extract. Some examples of other bioactivities that could be investigated in future are antiviral, bacteriostatic, antibiotic, mammalian cell growth stimulation, wound healing, and acting as a stabilizing agent, suspending agent, flocculating agent, encapsulating agent, emulsifying agent, and/or lubricating agent and volumizing activity.